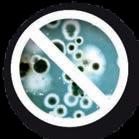
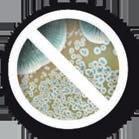

![]()





NON-CONTACT VOLTAGE TESTER
GVD 1000-17
Dual voltage range for versatile applications
Robust IP67 protection for toughest job sites
Reliable performance with automatic self-test


DIGITAL MULTI METER
GDM 600-15
Inverted LCD display
IP65-Rated for tough jobsites
Compact design with kickstand


VOLTAGE TESTER
GVT 1000-15
Voltage testing up to 1000 V AC/DC
Built for tough job sites: IP65 protection

CLAMP METER
GMC 600-15
Designed in accordance with IEC EN 61243-3:2014


FORK METER
GFM 1000-15


IP54 rating and impact resistant
Compact with magnet hanging solution
Measures up to 600A (AC) and 600V AC/DC
Measures up to 1000V AC/DC
IP54 protection with comfortable grip
Compact with magnet hanger solution














might not always make the headlines, but it’s where a huge chunk of the action happens.
From the dusty mining towns to the green farmland and buzzing country centres, these places keep the country ticking — and tradies are right there in the thick of it.
Out in the regions, every job counts.
As a born and raise Launcestonian, I can a est to just how undervalued regional Australia can be.
Whether it’s wiring up a new hospital wing, fi xing a dodgy pump on a farm, or ge ing a childcare centre off the ground, the work you do changes lives. It’s not always an easy gig — long drives, unpredictable weather, and a bit of
improvising come with the territory — but the payoff is massive.
You can see the difference your skills make straight away, and the community never forgets it.
Right now, the opportunities are bigger than ever. There’s serious government cash going into regional infrastructure, renewable energy projects are sprouting up everywhere, and housing demand is through the roof.
For tradies keen to get out of the city grind, that means solid work, cheaper living, and plenty of room for the kids to run around. But it’s not just about chasing jobs. Working in the bush or in small towns calls for a bit of grit and a lot of mateship.
Gear might take a while to arrive, weather can throw a spanner in the works, and sometimes you’ve just got to figure it out on the fl y.
That kind of can-do a itude is what makes regional tradies some of the best problem-solvers in the game.
This issue, we’re shining a light on some of those stories — from Tamworth to Castlemaine, Albany to

I was lucky enough to be a part of Carpentry Expo in September, having great chats with industry stakeholders
Devonport — we salute you!
Whether you’re a city sparkie or a country chippy, there’s plenty here to get you thinking about the opportunities beyond the big smoke. Regional Australia keeps the nation running. Back it, and you’re backing the future — yours included. Cheers!
EDITOR
Harry Murtough





EARTHMOVING
ACCESS
SITE SOLUTIONS
LANDSCAPING PUMPS
CONCRETE CARE
PLUMBING & CIVIL
POWER
LIFTING & MATERIALS HANDLING
TRAFFIC RAIL
CONSTRUCTION & SURVEY
...AND MUCH MORE
We wish we could balance four coffees in a tray like Jamie handles this rail
IMAGINE RIDING a wakeboard on a 140-meter rail at 34 km/h, 2,000 meters above sea level.
Sounds insane, right?
Well, Red Bull athlete Jamie Huser just pulled off this mind-blowing stunt on Lake Falerin in Switzerland, nearly doubling the previous record!
This Swiss rider’s achievement is not just about the length – it’s about the precision, balance, and persistence required to conquer a rail that’s almost ten times longer than standard competition rails.
Huser’s secret to success? Slowing down his mindset and making tiny adjustments to nail the perfect pace.
The footage of this epic ride is jaw-dropping, and Huser’s reaction says it all: “Indescribable. It felt like freedom,” he said.
“I was overwhelmed with emotion, full of joy.”
This 21-year-old phenom has redefined the limits of competitive wakeboarding and opened up new possibilities for the sport.
Hats off to Jamie Huser for pushing the boundaries of what’s possible on a wakeboard! This record-breaking ride will leave you speechless and inspired.







ETS has a hefty fleet of Trafics, ready to tackle a variety of tasks
There’s no shortage of work for Malcolm Farnsworth and the team at Electrical Testing Services (ETS). The national electrical compliance and safety business covers it all — from routine test and tag jobs to largescale retrofits, including medical installations, power
factor correction testing and switchboard upgrades. With such a diverse workload, ETS needs a vehicle that offers flexibility, reliability, and space to match the demands of the job. For Malcolm and his team, that vehicle is the Renault Trafic.

ETS NATIONAL Field Services Manager Malcolm has been with the business for 17 years, helping to drive its growth alongside founder Darren Brown, who started the company more than 24 years ago.
What began as a small test and tag service has evolved into a one-stop shop for electrical safety and compliance across Australia and New Zealand, employing more than 150 people.
“We’re a compliance company now — that’s the core of our business,” Malcolm said.
“The more services we can offer our clients, the less disruption for them, and the greater the savings. One team can do it all.”
Today, ETS services extend even further, now including the testing and maintenance of biomedical equipment in patient care areas. With triple ISO certification and NATA accreditation, ETS backs its highly qualified workforce with the most rigorous testing standards in the industry.
Trafic has been a mainstay for many tradie fleets, with ETS having about 30 vans for its team across Australia.
The work ETS does can take them anywhere and do almost anything, so they rely on a vehicle that can handle a big day’s work.

With the longest load length in its category, topping out at 4.15m, and a maximum cargo area of 6.7m3, tradies have the space they need to carry tools, materials, and equipment for a day’s work.
ETS’ Trafics are all long wheelbase variants and Malcolm lauded each van’s ability to fi t massive loads in it.
“We can be doing so much travelling in these vehicles, so they all have dual power supplies put in them, inverters and charging stations.
“Some jobs — you can be travelling for weeks on end, so each van has room for a portable fridge.
“The savvy tradies will actually pack enough supplies for two weeks, as well as all the equipment they need to service all the sites.
“For example, someone may need to go out an replace 18-20 fire extinguishers, then bring back the old ones.”
That capacity comes in handy when you add in Trafic’s compact exterior. A height of 1.97m helps tradies like those at ETS get to the job smoothly and conveniently.
“That [capacity] enables you to put longer items inside the van from the back all the way to the front,” he said.
“Height is such an issue these days; car parks are being made smaller and smaller.
“That’s what I like about Renault Trafic — it’s lower than other vans. We can still take a 3m ladder inside the van, which enables someone to get to high ceilings in shopping centres without having to park out on the road or get a loading permit.”
Not only does Trafic carry its fair share, it can also do so for massive distances.
The EDC automatic gearbox delivers an extremely economical 6.5L/100km on the combined cycle.
Paired with an 80L fuel tank and the 2.0L turbocharged engine, Renault Trafic can run long stints without needing a refuel.
Malcolm loved the mileage he gets with Trafic. When he’s needed to drive an van interstate to another site, he’s been able to do so in one tank.
“I’m so impressed with Trafic,” he said.
“I was taking a Trafic from NSW to our Queensland offi ce and the tank was giving me more kilometres before needing a refill the further I went.”
This means tradies spend less time at servos and more time ge ing work done.
“The team does a lot of kilometres in these vans because we service all of Australia,” Malcolm added.
When it comes to comfort over those long distances, Malcolm said Trafic had his team sorted.
Ergonomic seating and professional finishes make the interior a tradie’s dream whether they’re on the road or parked on-site.

“They’re an extremely comfortable van,” Malcolm said.
“The guys don’t get fatigued from driving them because of how ergonomic the seating layout is.”
The modular seating setup allows for configuration into a portable offi ce, perfect for those moments when you’re not on the tools.
“The centre seat folds down, and there’s a built-in station in the seat with a nice fl at area,” Malcolm said.
“Someone can pull out their laptop, complete a thermal report within their van or send photos of a job for example.
“It’s all there for them straight away at your fingertips and not inconvenient.”
ETS technician David Mallia is one of many tradies who appreciates the amount of equipment, tools and components they can fit inside their Trafic



Safety isn’t something a tradie might notice from the get-go, but that doesn’t make it any less important.
Thankfully, Trafic has the latest safety tech, including cruise control, optional traffi c sign recognition and blindspot monitoring, lane departure warning and active emergency braking. With 10 driving assistance systems all up, including driver a ention and drowsiness alert, Renault Trafic keeps tradies secure on the road.
“There’s so many safety features in these vehicles,” Malcolm said.
The dashboard is also well-equipped, featuring an eight-inch touchscreen with Android Auto, Apple CarPlay, DAB+, Bluetooth, and USB connectivity.
“All those smart features means guys aren’t using their phones, they can open maps and chart out location-to-location and those kinds of things,” Malcolm said.
It would be an understatement to say Malcolm was impressed with how Trafics have performed for ETS. He said his tradies had nothing but good things to say about their experiences with driving Trafics across the country doing a massive variety of jobs, all the while doing so with top-of-the-line fuel economy, comfort, storage and safety.
“I did a lot of research when it came to choosing the Trafic as our vans,” Malcolm said.
“There’s so many features that impressed me … there’s so much to like.”



Breathe easier. Ryco’s N99 MicroShield Cabin Air Filters have been developed with a medical grade N99 media technology to filter out pollen, allergens, airborne viruses, and bacteria as small as the H1N1/H3N2 influenza A virus.
Filtering down to 0.3 microns or greater in size, it prevents contaminants from entering the vehicle cabin that could potentially penetrate deeper into the respiratory system.
So, when your passengers need superior protection, be Ryco Ready.

SUMMER’S JUST around the corner, and you know what that means - it’s time to hit the water and catch some serious fi sh! If you’re an Aussie tradie who loves to boat, you’re probably looking for a vessel that’s gonna help you land the big ones and have a ripper of a time doing it.
That’s where the Bar Crusher Raider series comes in. These beasts are designed for serious fi shing on the continental shelf, out to off shore reefs and in the bays. You’ll find each boat is packed with the tools to make you a
fi shing machine.
“The Raider series puts a top-of-the-range premium package together for our customers,” Bar Crusher Sales Manager Ma Urzia said.
“They showcase everything we can possibly think of in terms of options and electronics to put in Bar Crusher Boats.”
If you’re looking for options, Bar Crusher’s got you covered with their range of Special Edition models, including the 670XT Reef Raider, 670C

Bay Raider and 670HT Shelf Raider. Each Raider is designed for specific fi shing applications, so you can choose the one that suits your needs.
“Each model is set up a li le bit different to suit the three of the main styles of fi shing our customers like to engage in,” Ma explained.
“The off shore game fi shing handled by the Shelf Raider. The Reef Raider (is) doing your more up north fi shing, casting poppers and lures out the front and sides, with a bit of bo om bashing too.
“Then finally the Bay Raider which is more suited to anchoring and fi shing in the bays.”
With its factory-fi ed Seakeeper RIDE 450
system, premium marine electronics, thermal imaging camera, and bowmount electric outboard motor, you’ll be ready to tackle even the toughest fi shing conditions.
The Reef Raider’s got a sick paint scheme, with a Satin Black hull and hard top, and Aircraft Grey side decks and inside the boat.
And with Shadow Chrome hull graphics, you’ll be looking like a boss on the water. But it’s not just about looks — this boat’s built for performance. Whether you’re a tradie looking to get away from it all on the weekends or a serious angler looking to land the big ones, the 670XT Reef Raider’s got you covered.
The bells and whistles keep coming across all three boats, with Ma stoked to be unleashing these three on Aussie anglers.
“We’ve put together
some really high-spec packages for our customers that demand the best of everything,” he said.
“Top-of-the-range alloy trailers with max load ratings of three tonne, fl y by wire electric shift Suzuki’s on all three models which come with Suzuki Position Control (SPC). They’ve also got Flir M232 thermal cameras and Doppler Radars.
“Then every other option we can possibly think of to go on a boat.”
Why se le for boring when you can ride in style and catch some serious fi sh with a Bar Crusher Raider? Get ready for summer and grab yourself a Reef Raider - you won’t regret it.




Rinnai’s new Electric Heat Pump range rinnai.com.au

Built to withstand Australia’s diverse climate, the Rinnai Enviroflo GR Series heat pump range uses high quality components and the latest technology to ensure reliable and efficient performance, every time.
Quiet Operations
Runs at a low 46dB(A).
PV Compatible
Can be networked into a solar PV system for more cost-efficient water heating. between -7°C to 45°C for installation Australia wide. requirements.





TRADIES WHO love hi ing the water know their boat is more than just a vessel - it’s their pride and joy. An investment in passions and a key part of their lifestyle.
Whether you’re casting lures at dawn or cruising along the coast, having the right insurance cover can make all the difference.
That’s where Club Marine comes in — Australia’s largest boat insurance provider, trusted by thousands of boaties across the country.
A COMMITMENT TO QUALITY AND SERVICE
With Club Marine, you become part of a community that understands the importance of taking the worry out of boating.
“I have a lot of pride for this boat [and] how hard I’ve had to work to own a boat like this,” Club Marine member Phil said.
“It’s one of my most important investments.”
Club Marine’s commitment to quality
and service is reflected in their high renewal rate, with close to 90 per cent of members choosing to renew their policies year after year.*
When you take out a Club Marine policy, you’re not just ge ing insuranceyou’re ge ing access to a range of exclusive benefi ts that enhance your boating experience. These include:
• Club Marine Assist: Get help when you need it most, with 24/7 roadside assistance for your vehicle and trailer.^
• Member Rewards Program: Enjoy discounts from a range of retail and service providers, tailored to your boating lifestyle.
• Club Marine Magazine: Stay up-to-date with the latest marine news and lifestyle tips with a discounted subscription to Australia’s leading marine lifestyle publication.
Phil’s experience with Club Marine’s claims process speaks to the company’s commitment to supporting its members.
After a mishap with his boat, Phil was impressed with the ease and simplicity of the process.
“Nothing was a problem,” he said.
“The assessor gave a very independent and honest report. It was a good experience. I got the correct support, correct guidance, for a good outcome.”
Whether you’re in a major city, or coastal town, Club Marine takes a local approach that is backed by deep marine expertise, with a trusted network of dealers, repairers, and assessors who live and breathe boating.
Club Marine’s dedication to the boating community extends beyond insurance. They’re proud sponsors of various competitions
and events, supporting the very activities that bring joy to their members.
“You like to see these comps do well. And without the support from the sponsors, the comps would not exist,” Phil said.
“We’ve had three comps down the south-east coast this year, and Club Marine’s been down there handing out the prizes and providing support. [It] sets them apart from the rest.”
Club Marine is commi ed to taking the worry out of boating, so you can focus on the fish, not the what ifs
If you’re a tradie who loves boating, Club Marine is the clear choice for your boat insurance needs.
With their commitment to service, dedication to making the process easy and industry knowledge, you can trust your beloved boat is in good hands. Join thousands of satisfied members and discover why Club Marine is the obvious choice for boat insurance in Australia.
Club Marine’s dedication to the boating community makes them the go-to choice for Aussie tradies who love boating


WHAT DO you do to make the best motocross bike be er? Yamaha’s engineers figured that riders don’t need any more power, instead they turned their a ention to making the fire-breathing MY26 YZ450F easier to ride. Because if a bike is easier to ride, it’s easier to ride fast.
Only elite riders demand the fierce power produced by an open class MX bike. Holding onto one for a 20 minute race demands skill, fi tness and stamina. Fast lap times are achieved when all the stars align which includes selecting the right line, finding traction, nailing jumps and railing berms. Yamaha’s YZ450F has been the benchmark in this respect for a few years now, as demonstrated by AMA SX

Champion Cooper Webb and a slew of US magazine shootout wins.
The YZ450F’s combination of big horsepower in a stable and sweet handling chassis has won plenty of fans over the years. But as far as tech goes, staying still in the MX development game is going backwards.
Every two years Yamaha takes a whole fresh look at their YZ250F and YZ450F motocross bikes and 2026 is the 450F’s turn. The factory meets with US and AUS/NZ testers to nut out the direction of the next model and their feedback leads to changes to the
bikes on the showroom floor.For example, when evaluating an MX bike, they break a corner down into three sections – entry, apex and exit. The bike needs to perform equally well in all three areas to get the thumbs up. It’s no good railing the entry only for the bike to push wide at the apex. Both wheels need to find traction all the way around the corner.
CONSTANT EVOLUTION
With this in mind, changes have been made to the MY26 YZ450F’s chassis and suspension. The aluminium chassis is flex tuned by adding
or removing metal in strategic locations. This controlled fill process adjusts lhe rigidity of the chassis in three planes – torsional or twisting, lateral and longitudinal. Engineers can then adjust the engine mounts – the shape, material and thickness of these can change the feel and feedback the bike gives to the rider.
These chassis changes, combined with an all-new shock absorber and front suspension se ings, result in a bike that turns quicker and easier with increased grip from both tyres. Other changes to the bike
The 2026 Yamaha YZ450F highlights its new flex-tuned aluminium chassis and updated suspension for quicker cornering and improved traction
include more controllable low-down power, a hydraulic clutch – at last – new bodywork and an anti-theft lockable ECU.
Aussie journalists put this to the test recently at Appin Motocross Complex in NSW. Team Monster Energy CDR Yamaha was on hand to run in the YZ450Fs and set them up for each of the 11 journalists who a ended. CDR riders Jed Beaton and Aaron Tanti were on hand fresh from an incident packed ProMX season – where Beaton led the charge for most of the year before a broken


femur in a practice crash dashed his title hopes. Tanti was still recovering from an early season broken neck and it’s fair to say that Team CDR have had more successful years, but that’s racing.
FACTORY BIKE EXPERIENCE
In addition to testing the standard YZ450F, journalists were offered the chance to ride Jed Beaton’s factory YZ450F race bike – they did not need to be asked twice. Works bikes differ to standard bikes to varying degrees but are essentially personalised to each rider’s style. And factory riders are on a whole different level to the club grade riders at your local MX track.
After a fun day riding Appin’s Bellbird track –the sun came out after a week of torrential rain – the consensus was that Yamaha has nailed the brief. The bike is indeed easier to ride than the previous model. Standard tyre fi tment is the high-performance Dunlop Geomax MX33 but
for the launch the Team Yamaha specified the more recently developed Dunlop MX34, a soft to medium trye with a new block design for be er mud evacuation, enhanced durability and traction. Testers also had a chance to change their own power mapping and traction control using Yamaha’s awesome smartphone tuning app – this can make your YZF go from mild to wild at the touch of a bu on. Your phone can store different maps to suit different tracks and can also log lap times, offer set up and maintenance info via the app. The bike can run two maps that are switchable on-the-fl y using the left-bar mounted blue bu on.
While it’s not an easy task to evaluate a bike and tyres without back-to-backtesting, the overall vibe from the selected testers was super positive. The weather played ball and the track was still soft in places - but fun. The 2026 YZ450F is
available in dealers now priced $15,749 inc GST ready-to-ride. Or for nostalgia fans, there’s a Special Edition version in a trick 70th Anniversary colour scheme at $15,949 inc GST ready-to ride dropping in November. The 70th Anniversary edition
celebrates 70 years since the first Yamaha rolled out of the factory and features a speedblock design similar to the one Doug Henry ran on his Las Vegas winning 1997 YZ400F –the bike that kickstarted the four-stroke dirt bike revolution.
Special Edition 70th Anniversary YZ450F in classic Doug Henry–inspired speedblock graphics celebrates seven decades of Yamaha innovation


AS WARMER weather arrives and homeowners look to transform their outdoor spaces, tradies are gearing up for a season of pergolas, decks, fences and retaining walls.
The need for a concrete that delivers both speed and strength has never been more important — and Cement Australia’s PROStrength® Rapid Set Concrete is rising to the challenge.
Made right here in Australia, PROStrength Rapid Set concrete hardens in around 30 minutes and is twice the strength of standard rapid-set mixes.
That combination of fast-se ing convenience and high-load durability makes it perfect for fencing, gates, retaining walls, sporting equipment installations and commercial signs.
For concreter Sco McDonald from Inspire Concrete, the product lived up to its name on a demanding balcony job in Mount Eliza.
“Mate this is awesome,” Sco said.
“It was easy to mix and work with – it didn’t start se ing too fast as well, it was the perfect amount of time to pour directly, mix and work it to get the shape right.” Sco added, “I want my work to be of a high-quality standard. These mixes get me exactly that.”
Elsewhere, carpenter Toby Spicer from Pillar Construction echoed that sentiment while tackling a 40-metre fencing and retaining wall project in Melbourne’s south-east.
“Other quick-se ing cements harden in about 15 minutes, which can be good but also doesn’t give you much wriggle room to work with,” Toby said.
“For my work, 30 minutes is the perfect amount of time to be able to properly pour, mix and pad out evenly.”
The product’s strength impressed him just as much.
“It was unreal, the concrete has really held up,” Toby said.
“We’re using 115×115 Cyprus posts at about 3.6m deep, so we needed something that was gonna hold up.
“Needless to say, it did the job and we were thoroughly impressed with the final product.”
DONE RIGHT
Paul Cunial of APC Landscapes was able to set his posts and install the panels in the same day using PROStrength Rapid Sety Concrete when working on a heavy-duty fence in Brisbane.
“If I had to do this with any other product,
Sco and Toby pouring PROStrength® Rapid Set
whether it’s a rapid set or normal concrete, I would still be se ing posts tomorrow, if not the day after.
“It’s very important because it allows me to move on to another project tomorrow.”
With its ability to be poured directly into the hole before adding water — no pre-mixing required — PROStrength Rapid Set allows tradies to complete jobs faster and move on to the next site sooner.
As Toby summed up, “we strive to use the best products at our company, and this cement is definitely up there.”
This spring, when speed and strength are equally essential, Cement Australia’s PROStrength® Rapid Set Concrete ensures tradies can say: Same Day? Job Done.
Concrete for their outdoor jobs, confident in the cement’s 30-minute set and 40 MPa strength PROStrength® Rapid Set; ready to tackle the next stage of his outdoor reno





















HBT is Australia’s largest buying group of independent stores within the Hardware, Building Supplies, Industrial, Paint, Rural, Garden and Timber categories.
We give local businesses the power to stay competitive –negotiating better deals, securing access to major suppliers, and supporting the kind of service you can’t find in a warehouse.








We know tradies rely on the local community, just like us.
When you shop at a HBT store, you’re not just backing a local – you’re tapping into the power of hundreds of independents who have joined forces to beat the big boys on price, range and service.
We’re not owned by a corporate. We’re backed by something stronger: each other.






IF YOU haven’t heard of Senix yet tradies, now’s the time to check them out.
Looking for tools that can mix it with the top-tier brands quality-wise, while also not burning a hole in your wallet?
Get a load of Senix.
“Premium performance at excellent value” — that’s how Senix Australia Vice President Tim Paton described it.
“Although Senix offers a price that is excellent value, our tools spec right up into heavy trade.”
Senix might have only recently touched down in Australia, but the brand is no stranger to impacting the global trade landscape offering solutions across both Power Tools and OPE through their X2 18V, 2X2 36V, X6 60V, Petrol and Corded ranges in the US and in Europe for years.
Tim said the brand was excited to provide a new option to the unique Aussie tradie market.
“I think the Australian market and consumers have always been very savvy in terms of being able to look at the brand, look at specs, look at the price, and weigh those three things up and make it a fairly considered decision when they make their purchase,” he explained.
MIX IT UP
Senix has a massive range of 18V power tools as part of its X2 range that’ll pique any tradie’s interest.
Tradies like Paul Swann; a carpenter working for Done Right based in Melbourne’s east.
From bathroom renos to maintenance and warranty work, his work takes him to all kinds of jobs.
Paul had a chance to put
a few Senix tools through their paces and loves what he’s seen so far.
“Senix is ahead of the game in that aspect,” he said.
“They’re giving the tools to tradies to try them, give them a good run, and give Senix the feedback on what they need to improve to eventually come into the market with a great tool.”
Drivers, saws, drills — you name it, Senix will have it as it deploys its range Down Under.
A chippy with 14 years under his belt; Paul’s been around the block a few times with plenty of Australia’s favourite tools brands.
He said the Senix products he’s used have been equal to, or in some cases, be er than the other brands.
“We wanted to make sure that tradies are ge ing a product that is fi t for purpose and will
outperform some of the bigger boys in the market,”
Tim added.
“Now we may not have the width of range of some of those brands, but we’ve always maintained our strong focus is on ensuring we have that core foundation of tools that every tradie needs, day in day out, with top endspecs at a great price.”
“We do this core as well as anyone in both Power Tools and OPE.”
SAVE THAT DOSH
As Tim mentioned, the quality of Senix’s tools doesn’t come at a high price point at the checkout.
Despite their comparison
a single-point depth adjustment (up to 63mm)
to other well-known quality brands, going with Senix can save hundreds for tradies.
“For tradies, that’s something we really look at,” Paul said.
“You don’t want to go for the cheapest option on the market because it’s not going to hold up.
“But Senix is worth it, and sometimes it’s half the price of the other brands.
“If you can save money and get a be er tool, it’s almost a no-brainer isn’t it?”
If you’re a tradie keen to give a new brand a go that’ll save you cash without compromising quality, check out Senix as it expands its footprint in Australia.
18V ba ery-powered tools can keep up with other well-known brands



AUSTRALIAN TRADIES
continue to push the boundaries of decking installations, awesome innovations like the Trex RainEscape deck drainage system are revolutionising the way we design and build decks.
This game-changing system allows homeowners to double their functional outdoor space by diverting water away from elevated decks, creating dry and usable areas underneath.
KEY FEATURES AND BENEFITS
The Trex RainEscape system boasts several key features that make it an essential component for any deck-building project. The biggest selling
point for tradies and their customers is RainEscape’s unique above-the-joist installation.
The discreet drainage system uses a series of troughs to keep the deck dry. Because of this design gas and electrical lines can be run through the deck if needed. Additionally, it allows for more room under the deck — a major selling point for customers wanting to use that space.
Tradie Tristan Smith runs Nail It Construction in Sydney’s Northern Beaches, and does 100s of decking jobs every year.
“A lot of the projects we get called up for are people who are trying to gain space underneath an existing deck that they’ve got, or they’re wanting
to install a new deck over a balcony area, and they want the underneath of the deck to be completely watertight,” he explained.
“So a lot of projects that are spec’d for under-deck storage, or they’ve got a gazebo underneath or some sort of area that they want to still have as a living space.
“That’s where we’re finding people clients are wanting to use Trex RainEscape and the benefi ts that come with it.”
Not only is RainEscape super innovative, but it’s also simple to install, with tradies only needing a utility knife, staple gun and caulk gun.
“As the only product on the market that’s an over the deck, over the joist
system, it’s easy to install from above,” Tristan added.
“It is simple; once you’ve done one or two, you can really understand the process.”
Those installing RainEscape can also do so knowing it’s backed by a 25-year limited warranty.
For those who build decks regularly like Tristan, the Trex RainEscape system offers a range of benefi ts, including:
• Increased functionality and liveability of outdoor spaces
Tristan from Nail It Constructions has used RainEscape on loads of his projects, with his team and customers alike loving the installation process and extra space it creates
• Protection of deck foundations from moisture penetration and rot
• Added storage space underneath the deck
• Flexibility to design and build unique outdoor living areas, such as al fresco dining areas, hot tub havens, or entertainment spaces
TREX PROTECT: AN ADDED LAYER OF PROTECTION
The Trex Protect system provides an additional layer of protection for deck joists, rim joists, ledger boards, and bearers. This butyl-based self-adhesive sealant:
• Shields deck components from moisture and rot
• Acts as a barrier between timber and galvanised metal construction hardware
• Seals deck fasteners and helps deck screws hold longer and stronger
By incorporating the Trex RainEscape system and Trex Protect into their deck-building projects, tradies can create outdoor living spaces that are not only beautiful but also functional, durable, and protected from the elements.











Want extra cover but don’t want to muck around arranging multiple policies? We’ve got you sorted. We protect trucks & equipment that keep tradies moving with comprehensive motor cover, downtime cover, and 24/7 roadside – all in one, with the option of including Public & Products Liability, Goods in Transit, or Work Tools Cover, where eligible.*
Get an instant quote from truckassist.com.au today.



EVERY TRADIE knows the frustration: one stripped bolt, rounded nut, or stuffed thread and suddenly the whole job stops dead.
Doesn’t ma er if you’re on the tools in the shed, under a truck, or out onsite — a damaged thread can turn a quick fi x into a long, expensive headache. Up until now, fi xing threads has meant mucking about with taps, dies, or inserts. Slow, messy, and half the time you’re left wondering if it’ll even hold under load. That’s where the ThreadSaver by Silbertool changes the game.
Brought to Aussie
workshops by Warren & Brown Tools, ThreadSaver is a tough, precisionengineered bit of kit that repairs damaged threads properly — without cu ing, grinding, or weakening the part. It’s a smarter, faster, and stronger way to get your gear back in action.
WHY THREADSAVER’S A GAME CHANGER
• Fast: Brings busted threads back to life in seconds, not hours.
• Non-destructive: No cu ing, no grinding — it reforms the metal back to its original shape.
• Save your parts: Don’t chuck expensive gear in
the bin. Restore it and keep working.
• One tool, endless uses: Designed to work on both internal and external threads across a huge range of pitches and sizes. From truck axles and trailers to farm machinery and classic engines, ThreadSaver keeps you on the tools and keeps the job moving.
HOW IT WORKS (SIMPLE AS)
1. Choose the right rollers for the thread size.
2. Oil up the damaged area.
3. Clamp the tool down by hand with an allen key.


4. Spin it around the thread.
5. Done — thread’s back good as new. No power tools needed, no dodgy workarounds — just reliable, repeatable results every time.
BUILT FOR AUSSIE WORKSHOPS
This isn’t a gimmick. ThreadSaver is built tough for real tradies working in the real world. Whether you’re a mechanic, fleet tech, truckie, or farmer, it’s designed to handle
Repair damaged threads properly — without cu ing, grinding, or weakening the part
the kind of hard, dirty, day-in-day-out jobs that break lesser tools. Strong, accurate, and ready for whatever you throw at it.
READY TO SAVE YOUR THREADS?
The ThreadSaver by Silbertool is in stock now at Warren & Brown Tools. Use coupon code TRADIE to score 10 per cent off your next order!














WHEN BUILDING or renovating, you want a plasterboard that is not only easy to install but also delivers long-lasting performance.
Knauf’s new SHEETROCK® PLUS is a premium 10mm plasterboard engineered specifically for the demands of modern residential construction. It combines impact resistance, water resistance and acoustic performance into one board, making it an ideal solution for a variety of projects.
BUILT FOR PERFORMANCE AND DURABILITY SHEETROCK PLUS is designed to withstand the
wear and tear of high-traffi c areas and spaces that need extra strength.
Its core is reinforced with fiberglass and is denser than standard plasterboard, which gives it enhanced impact resistance.
This means it can handle accidental impacts from furniture or an errant kick.
This product is also made with a waterresistant core, making it a great choice for moisture-prone spaces like kitchens, bathrooms, and laundries.
It’s even suitable for external protected ceilings, such as those in alfresco areas and garages in non-cyclonic regions.
A QUIETER HOME WITH HIGH ACOUSTIC PERFORMANCE
Noise transfer can be a major headache in multiresidential buildings such as townhouses, and duplexes.
SHEETROCK PLUS is a high-density board that offers excellent acoustic resistance helping to reduce noise between adjoining rooms.
It’s engineered for use in Knauf PartiWall and other acoustic systems, helping you create quieter and more comfortable living environments.
Beyond multi-family housing, this makes it a great choice for residential spaces where noise reduction is a
priority, such as media rooms and home offi ces.
ENVIRONMENTALLY CONSCIOUS AND VERSATILE
In addition to its performance benefi ts, SHEETROCK PLUS is manufactured in Australia to meet the high standards of AS/NZS 2588:2018 Gypsum Plasterboard.
Knauf uses a combination of natural gypsum and paper liner made from reclaimed and recycled paper waste.
The product has multiple certifications, including GECA (Good Environmental Choice
SHEETROCK PLUS: premium 10mm plasterboard that combines impact resistance, water resistance, and acoustic performance for modern residential construction
Australia) certification and Climate Active Opt-In certification. These certifications may also contribute to Green Star credit points for your projects.
When it comes to installation, SHEETROCK PLUS works with Knauf’s range of jointing and adhesive compounds.
It’s also suitable for tiling surfaces up to 32 kg/m2.
Knauf SHEETROCK PLUS is a versatile and robust solution that seamlessly blends technical excellence with practical benefi ts - a product that does more.
It’s the perfect choice for builders and plasterers to deliver resilient, quiet, and comfortable spaces that meet the rigorous demands of modern construction.
For further details on installation, safety, first aid, or technical specifications, you can find the relevant safety data sheets and additional resources on knauf.com Check it out!

AS WINTER’S chill gives way to the fresh bloom of spring, Aussie tradies are gearing up for their busiest season.
More and more tradies are getting into garden work, maintaining public spaces, or managing large green properties.
So having powerful, reliable tools is not a luxury — it’s a necessity.
Bosch has met this
need with a robust lineup of six new professional outdoor power equipment (OPE) tools to add to their existing range. These are designed to make garden and landscape work faster, easier, and cleaner. Here’s how these tools are set to transform springtime productivity for Aussie tradies and green thumbs alike.
GGP 12V-25
PROFESSIONAL PRUNER
Don’t be fooled by its compact size — the GGP 12V-25 cordless pruner is a precision powerhouse.
Weighing in at just 0.83 kg (without battery), it’s ideal for prolonged use without fatigue.
Capable of slicing through branches up to 25mm thick, it’s tailor-

made for pruning shrubs, bushes, and fruit trees — just the kind of tasks that become high-priority in spring.
Its compatibility with the Bosch 12V Pro system means tradies can integrate it seamlessly into their existing toolkit, and with up to 4,500 cuts per charge (with a 3Ah battery), it’s built for all-day work without interruption.
GBL 18V-800
PROFESSIONAL AXIAL BLOWER
Spring brings fresh growth — and a fresh mess.
The GBL 18V-800 blower is a serious step up for outdoor cleaning.
With an impressive airflow rate of 800m³/h and speeds of up to 200km/h, it’s a dream for clearing leaves, trimmings,
GGP 12V-25 Professional Pruner: compact, precise, and powerful. Prune with ease and tackle spring growth with confidence
and debris from large or hard-to-reach areas.
Its variable speed control lets tradies fine-tune power, noise, and runtime for the job at hand, while attachments like the concentrator and flat nozzles offer versatility for different surfaces. The trigger lock reduces fatigue during extended use — especially handy on large properties or those big-time commercial jobs.
GRT 18V-40
PROFESSIONAL GRASS TRIMMER
The GRT 18V-40 cordless grass trimmer is engineered for precision and endurance.
Its 600W brushless motor reaches cutting speed in less than a second, while a 40cm cutting diameter makes short work of overgrown
GHE 18V-50 TP Professional Pole Hedge Trimmer trims high hedges with finesse and power. Adjustable angled head and telescopic pole for added versatility
lawns and tough weeds.
A massive feature is Bosch’s Anti-Tangle technology — which automatically unwraps long grass or weeds from the motor for uninterrupted cutting.
Combined with a 360° adjustable D-handle, dual-mode trimming and edging, and variable speed control, this trimmer is primed for professional use in demanding environments.
GKE 18V-25 TP PROFESSIONAL POLE CHAINSAW
High tree branches often mean ladders, risk, and time.
The GKE 18V-25 TP professional pole chainsaw removes the ladder from the equation with a 2.9m telescopic pole, giving tradespeople safe access to lofty limbs. Its brushless motor, variable speed, and Oregon chain combine for clean, efficient cutting, while the design includes a branch hook for removing pesky stubborn debris.
It’s quiet and maintenance-friendly — a must-have for tree maintenance this spring.

GHE 18V-50 TP PROFESSIONAL POLE HEDGE TRIMMER
High hedges require finesse, reach, and power.
The GHE 18V-50 TP pole hedge trimmer brings all three, thanks to a 2.5m telescopic pole, adjustable angled head, and Bosch’s Anti-Blocking System that prevents jamming of thicker branches.
Its 23.5mm tooth opening and 50cm blade allow for swift trimming of large hedges, while the variable speed trigger ensures accuracy and efficiency.
Like others in this Bosch range, it’s clean, quiet, and splits into two parts for easy transportation.
GKE 18V-20 PROFESSIONAL PRUNING SAW
When space is tight but
cutting power is nonnegotiable, the GKE 18V-20 professional pruning saw gets the job done.
With the capability to handle branches up to 18cm, it’s perfect for pruning, limbing, and light construction cutting tasks.
Its gyro sensor technology activates chain brake if kickback is detected, adding a valuable layer of safety, while automatic chain lubrication and toolless chain tensioning keep the tool running smoothly.
At just 1.8kg, it’s one of the most manoeuvrable pruning saws in its class.
BUILT FOR THE JOB: BOSCH’S UNIFIED POWER PLATFORM
A major advantage across this entire Bosch OPE lineup is compatibility with the Bosch Professional 18V
System and AMPShare battery alliance.
Whether you’re a solo tradie or part of a landscaping crew, the ability to use a single battery system across multiple tools reduces downtime, streamlines your gear, and keeps the workflow smooth.
SPRING INTO WORK
Spring is a season of growth — and with growth comes demand. Australian tradespeople working in landscaping, garden maintenance, and arboriculture need tools
that offer power without petrol, reach without risk, and efficiency without fatigue.
Bosch’s outdoor professional tools are cleaner, quieter, and smarter — perfect for both commercial and residential work in modern, eco-conscious Australia.
Whether you’re tidying up a courtyard or maintaining a public park, these six new tools added to the range offer the performance and reliability professionals demand when it matters most.
Check it out! Check it out!
Find out more about all these epic OPE tools online
Be sorted with Bosch’s latest OPE range as spring and summer roll in


Sticks like sh*t – it’s something tradies say all the time, but this time it’s in the literal sense.
Bostik doesn’t beat around the bush with its Sticks Like Sh*t All Weather Adhesive

BRAND:

AN ADHESIVE with a load of applications is something every tradie worth their salt should have in their toolbox.
Sticks like Sh*t is an all-weather hybrid technology grab adhesive that doesn’t mess around.
It’s exactly the kind of product Eloise ‘El’ Wilson from Blue Form Projects needed for her project in Mornington.
Not only that; fellow chippy Nathan ‘Nath’ Dowell from Nudg1e Constructions also helped out testing Sticks Like Sh*t at his site in Huntingdale, in Melbourne’s south-east.
El was doing some renos to her nan’s place and needed Sticks Like Sh*t for a number of adhesive jobs from a aching security cameras to eaves and glueing down concrete tiles.
Thanks to some late winter rain, the site had plenty of porous surfaces. But that was no dramas for Sticks Like Sh*t, which can still be applied to wet substrates.
“It performed awesomely on the concrete slabs,” El said.
“They were really damp in the Melbourne winter, and it still stuck.”
While Sticks Like Sh*t does cure quickly, El said cleaning up any excess was clean and simple.
“It’s not messy and easy to wipe off, I really liked that,” she said.
“I just got a wet rag and gave it a quick flick and there ya go.”
“It leaves a clean final product — no nails — I’m really pleased with it.”





Whether you need an adhesive for masonry or timber, this gets the job done It leaves a
At Nath’s site, he needed Sticks Like Sh*t to stick down some yellow tongue flooring onto timber frames.
Much like El’s site, the dampness from a night’s rain had no impact on Nath’s ability to apply the adhesive.
“Not only that; knowing that Sticks Like Sh*t is unaffected up to 90 degrees is pre y impressive,” he said.
“If you’re working with that kind of heat, it’s good to know it can withstand that.”
After laying down the yellow tongue, Nath checked back later to find Sticks Like Sh*t had performed fantastically in curing quickly and holding well.
“It’s really handy that you can use it on so many things,” Nath said.
“Especially in construction, whether you need an adhesive for masonry or timber, this gets the job done.”
Both El and Nath were blown away by just how many applications Sticks Like Sh*t could be used for.
Whether it’s wood, metal, brick, glass, concrete and whether it’s tiling, fi ings, or even just repairing some ceramics — this stuff gets the job done.
“When it’s on, it’s on,” El said.
“Once you’ve got it where you want it, come back an hour later and it’s all set.”
GET IT NOW
You can find Bostik’s Sticks Like Sh*t at your local hardware store

El and her team used Sticks Like Sh*t has a massive range of applications.
Nath was able to cleanly apply Sticks Like Sh*t to his timber and yellow tongue. No muss, no fuss


The last thing a sparky, or any HVAC&R tradie needs, is a tool that makes their job more complex than it already is. Bosch is coming to the rescue with its GDM 600-15 Professional Digital Multimeter, simple and effective while built tough for Aussie conditions


A MULTIMETER is one of the most versatile tools a tradie has. It’s the ultimate piece of kit for detecting faulty wiring, testing circuit board integrity or many other maintenance tasks.
TEST #1: DIALLED IN
Dean used the multimeter on a number of outlets and appliances, checking voltage amperage, resistance and continuity.
Compared to his old multimeter, Dean loved the different options on the GDM 600-15 which helped tailor each test to his needs.
“You’ve got your voltage, for both AC and DC, and your resistance and amperage … but you can also check your test results and change the range all from the palm of your hand,” he said.
All the info was easily viewable for Dean thanks to the multimeter’s LCD screen that makes taking readings a piece of cake.
“When you turn it on, you get this big screen,” he said.
“Even if you’ve got the sun banging down on your testing, you can still easily see the results.”
While Dean has plenty of experience up his sleeve, he loved the overall simplicity of the multimeter.
“It’s your one-stop-shop,” he said.




“If you’re an electrician, whether qualified or an apprentice, you can walk into any job knowing you’ll be able to test safely and with confidence.
“You’ve got everything here that you need.”
Bosch has added plenty of bells and whistles to the GDM 600-15 that just make sense.
Dean loves the magnet a achment on the multimeter, which meant he could a ach it somewhere accessible while he went about his work.
“You can comfortably test with the unit while keeping it clean and off the ground and out of your pocket,” he said.
“Just chuck it onto any metal surface, and away you go.”
As well as the magnet, the multimeter also has an in-built kickstand, adding to the plethora of hands free options tradies have.
An IP65 rating means this multimeter is also built tough for when the job requires a bit of extra hard yakka.
“The durability and IP65 rating really stood out to me,” Dean said.
Not only that; Dean also loved the dual ba ery system meaning you can use two AA ba eries or a Bosch 3.7v 1Ah rechargeable ba ery made for equipment like the multimeter.
The GDM 600-15 also comes with its own durable silicone measuring strips.
This multimeter is part of a larger release of tools aimed at Aussie electricians, including voltage testers and meters. The GDM 600-15 Professional Digital Multimeter is an indicator of function and form Bosch is taking with this range, adding a bunch of smart design features with a straightforward user interface that left Dean loving it.
“It’s the bees knees,” he said.
“It’s performed fantastically, 10/10.”
CHECK IT OUT
Find out more by searching the new Bosch GDM 600-15 Professional Digital Multimeter online.
The durability and IP65 rating really stood out to me
You can walk into any job knowing you’ll be able to test safely and with confidence

Dean was blown away by just how many types of tests he could perform with one tool
An in-built kickstand makes it a cinch to set down the GDM 600-15 and still easily view readings
The simple design of the GDM 600-15 means simple interface with tonnes of options for electricians


Wireless Sensor Kit S102XK and Universal Catch Can Kit RCC360K
As the weather warms up, tradies are gearing up their utes and 4WDs for some epic 4X4ing. Even the most beastly of rigs can be undone by a lack of quality parts under the hood such as filters and separators
THAT’S WHERE Ryco comes in — these guys don’t mess around when it comes to delivering the best in filtration.
This includes the Ryco Universal Fuel Water Separator Kit and accompanying Sensor Kit as well as the Ryco Universal Catch Can Kit.
Tradie and LandCruiser lover Zac Fiddelaers gave us a hand with this Tradie Tough Test.
His 2017 GXR 200-Series Cruiser has a 4.5 V8 TD with twin-locked 35s and a remap pushing 230 horses.
In other words: it’s an expensive vehicle.
The last thing Zac wants is engine trouble caused by contaminated fuel or water wreaking havoc in the middle of nowhere.
He installed these kits and gave them a run through on some forest tracks in Noojee, eastern Victoria.
When you’re out in the regional/remote areas of Australia, you’re often at the mercy of the elements.
You’re also at the mercy of your fuel reserves or whatever you can find nearby, which mightn’t be as high quality as the stuff you get from your local metropolitan servo.
That’s where Ryco’s Universal Fuel Water Separator kit comes in handy.
This filter ensures debris and water is removed — with an effi ciency of 98.7 per cent — before fuel enters the critical components of the engine.
For someone like Zac, who takes his LandCruiser to some of the most isolated (not to mention soggy) spots in south-east Australia, having a filter like this helps give

Installing the sensor was easy for Zac, who could connect the sensor to the fuel separator and monitor via Bluetooth or a sensor light connected to the cigare e lighter plug





him the reassurance that his engine is almost totally protected from contaminants.
“It gives you peace of mind that if you do have crummy fuel, it’s not going to destroy your motor,” he said.
Ryco’s taken filter monitoring a step further with the sensor kit. Zac was able to easily hook this up to his 12v cigare e port in his console, no extra drilling or cablework required.
Zac could then check the status of his Ryco filters remotely via an app on his phone.
“It was really easy to hook this up and connect my phone,” he said.
“If you have a smartphone and use apps, you can use this.”
Tradies — including Zac — are no strangers to making modifications to their rigs. Modifications, engine wear and demanding driving conditions can affect gas flow.
This catch can helps prevent gases from contaminating engine air intake components, removing things such as crankcase emissions down to 1µm (micron).
“That catch can helps save all that extra oil going back into the intake of the engine,” Zac said.
The large sump capacity of the catch can means longer drain intervals so Zac doesn’t have to worry about it while he’s on long getaways.
This smart piece of kit also has an exterior service indicator, which gives someone like Zac the heads up that his catch can is in need of service.
Off -roading enthusiasts want to know they’ve done all they can to prepare their pride and joys for a demanding trip.
Ryco has a tonne of filters and filter-monitoring components that give tradies like Zac the confidence to hit the trail knowing their engines are well protected.
Head over to rycofilters.com.au to learn more about Ryco’s filters and components

Like many tradies, Zac loves taking his LandCruiser off the beaten track to places like Noogee
4WD and ute owners across Australia make modifications to their rigs, which means engine monitoring all the more


Builders across Australia have to deal with some of the harshest and most varied conditions there are.
For exterior screws that are up to the challenge, you can’t do much be er than Buildex® Bugle Ba en Screws
BRAND:


IT MAY be small, but it is crucial; choosing the right screws for the job can be the difference between a high-quality build and poor workmanship.
Tradies want to know they’re using the best when it comes to reassuring their customers, and the new Buildex Bugle Ba en Screws are top-of-the-line.
From the complete design, to the unique material innovations, there are plenty of reasons for tradies to pick these up and never look back.
Nathan ‘Nath’ Dowell from Nudge Constructions is one such tradie who had a blast with these screws.
Working at a residential job in Huntingdale, Melbourne, Nath needed the Buildex® Bugle Ba en Screws for laminating LVL beams, screwing down packing material and a bit of timber-steel brace work.
TEST #1: IN THE DETAILS
The Buildex Bugle Ba en Screws feature a few handy coating innovations that separate them from the pack.
This includes the ClimaShield® Class 4 coating, which keeps each screw protected from the harsh and varied Aussie outdoors and offer top notch corrosion resistance.
“These outlast galvanised screws – that’s really good,” Nath said.
“When comparing these to standard bugle screws,





the Buildex® Bugle Ba en Screws killed it.”
These protections mean reduced wear and extended lifespan, which equals a happy customer(s) for the tradie.
In addition to framing, the Buildex® Bugle Ba en Screws are ideal for outdoor projects like fencing, gates, pergolas, and landscaping.
When it comes to the Buildex Bugle Ba en Screw’s overall design, tradies will love it.
The Dual Type 17 Tip is designed to pierce timber twice as fast as standard ba en screws.
“I’m rather impressed … they drive nice and quick,” Nath said.
“We put them to the test against a competitor, and they were definitely quicker, that’s for sure.
“Speed is important in this job, and saving even a few seconds adds up over time.”
Not only are these screws designed for quick application, they also penetrate like pros.
The Dual Type 17 Tip also reduces the risk of spli ing timber, while the Hex 5 recess allows for be er grip and torque transfer.
Add to those a built-in clearing thread that boosts clamping power, and tradies will get a high-quality screw every time.
Aussie conditions demand trade materials that can handle anything and everything that’s thrown at them.
Through genius design, The Buildex Bugle Ba en Screws offer tradies a product that works quickly and performs great.
“The ease of use for these is great,” Nath added.
“There’s no mucking around, they go into the timber quick and clean.”
These screws are 14G and come in seven different lengths from 50-200mm.
GET IT NOW
now at your local Bunnings store
Saving even a few seconds adds up over time

Buildex® Bugle Ba en Screw packs come with a driver bit for added convenience


CONTRACTORS ARE no strangers to risk.
From going out on your own and building your business, to all the day-today site work you need to be on top of.
Whether you’re working on a high-rise construction site or in a customer’s home, accidents can happen.
That’s where BizCover’s Business Insurance Packs come in — a tailored solution that helps you manage multiple risks and protect your livelihood. There’s a range of cover options to choose from in the Business Insurance
Pack, so let’s unpack them all so you can choose what’s best for you.
TAILOR YOUR PACK TO YOUR NEEDS
With over a dozen cover options to choose from, you can tailor a Business Insurance Pack that fi ts your unique needs. Some of the cover options include:
• Portable Equipment: Protect your tools and stock from theft, fire, and other listed events.
• Contents: Cover your stock and business contents against fire and other perils.
• Theft: Protect yourself against loss of contents and stock due to theft or a empted theft.
• Building: Cover your owned business buildings from events like fires, storms and wind damage.
In addition to protecting your physical assets, BizCover’s Business Insurance Packs also offer cover options to help address new potential risks that come with managing and growing your business.
These include:
• Statutory Liability: Covers costs, fines, and penalties resulting from unintentional breaches of key legislation.
• Tax Audit: Cover for accountants’ fees incurred in connection with an audit by the Australian Taxation Offi ce.
• Employment Practices Liability: Covers employment-related claims against you, such as wrongful dismissal, bullying, harassment or discrimination.
• Employee Dishonesty: Coversloss of money and contents caused by theft, fraud or dishonesty by employees.
Compare policies and buy cover online in minutes – instant cover, no paperwork, no hassle.
• Save Money: Comparing and reviewing your insurance could uncover be er-value policies, saving you money that can be reinvested in your business.
• Get Rewarded: Earn Qantas Points on new eligible policies, thanks to BizCover’s partnership with Qantas Business Rewards.
TRUSTED BY OVER 270,000 SMALL BUSINESSES
BizCover has helped thousands of tradies and small businesses protect their assets and livelihoods. With a range of trusted leading insurers to choose from, you can compare multiple free quotes and buy online or over the phone in minutes. Get covered instantly, and receive your policy documents straight to your inbox.
Don’t let insurance management become a mess — streamline your business with BizCover’s Business Insurance Packs.










Work smarter, not harder. Simplfy your build and free up time when you use the single high-performing SHEETROCK® PLUS 10mm Plasterboard with three added benefits in one: water, impact, and acoustic resistance.
A smart all-in-one board for residential wet areas, acoustic walls and more, SHEETROCK® PLUS is Australian-made and GECA accredited, perfect for renos and upgrades with easy order and delivery.



ELECTRICAL COMPLIANCE on site
isn’t optional — it’s an obligation.
One of the simplest ways to deal with it is through test and tag training.
Test and tag refers to the process of inspecting and electrically testing portable appliances to make sure they’re safe to use.
It’s a core part of any workplace’s electrical safety compliance, especially in high-risk environments like construction sites.
And importantly, it’s one of the few compliance tasks that doesn’t require a licensed electrician — just a trained, competent person under the AS/NZS 3760 standard.
In just one day, a worker can become qualified to test and tag electrical equipment — helping their team stay compliant, avoid
costly downtime, and most importantly, protect lives.
The value of Test & Tag Training becomes even clearer when viewed against the current industry backdrop.
Australia is in the middle of one of the worst labour shortages in decades, particularly across construction and the trades. Master Builders has warned of a 130,000-worker shortfall*.
Arcadis reports 41,000 workers are needed* in Brisbane alone, and the AFR recently stated that 18,500 extra building workers* are required just to meet national housing targets.
The Housing Industry Association (HIA) has echoed the same concerns.
While Queensland is the
hardest hit, the skills gap is also being felt across states like NSW and WA.
Governments are trying to fill this gap quickly, fasttracking apprenticeships and training programs.
But this rapid infl ux of new and often inexperienced workers brings its own set of risks — especially around site compliance and safety protocols.
Testing and tagging is often one of the first safety steps to fall off the radar on busy or underresourced sites.
Site managers and supervisors are already juggling labour shortages and aggressive project deadlines.
Add new workers unfamiliar with test & tag obligations into the mix, and the risk of expired tags and untested gear
increases sharply. Missed test tags might not seem like a big deal — until someone is injured, or the site is shut down during a safety audit.
Here’s the good news: test and tag is one of the easiest compliance responsibilities to take care of in-house.
Any business can train one or more team members to become a ‘competent person’ under the standard — and start testing and tagging without any electrical experience.
By training someone internally to handle this task, businesses can:
• Ensure compliance without needing an electrician
• Save money and reduce reliance on external contractors
• Minimise downtime and avoid disruptions
• Boost overall site safety and confidence
As Australia’s largest provider of nationally recognised test and tag courses, Test & Tag Training helped thousands of tradies, contractors, and site managers bring this essential task in-house.
• Courses are available nationwide — face-toface in every state or online
• You can become qualified in just one day
• 2,500+ 5-star reviews and counting — the highest-rated test & tag training fi ve years running
• Lifetime technical support — always have access to expert help
• Onsite training available — we tailor courses to your business or industry
A PRACTICAL STEP FORWARD
In a climate where the pressure is high and experienced labour is hard to find, smart businesses are taking control of what they can.
Test & Tag Training is a low-cost, high-impact way to strengthen safety and compliance — without slowing down projects or overburdening your team. Equip your tradies with the skills to protect your site, your reputation, and your workers.

MICHAEL HIGGINS has spent over 13 years in residential construction across the Sutherland Shire and Illawarra, specialising in high-quality
outdoor living spaces.
Despite his hands-on expertise, the back offi ce was a different story — he juggled Word quote templates, spreadsheets,
and paper diaries, and most of the job info was stuck in his head.
As soon as business picked up, he found himself drowning in admin.

ENTER NEXTMINUTE
Michael saw right away that the platform was built for tradies like him — clean, simple and powerful, without all the unnecessary fl uff.
He particularly loved the quoting and cost tracking tools. Suddenly, quoting went from a chore to a few clicks.
More importantly, Michael gained clarity on which jobs were profi table and stopped scrambling for timesheets or chasing missing info.
Be er crew communication followed
— crew members logged hours easily, tasks were clearly assigned, and the daily workflow became calmer and more predictable.
MICHAEL’S VERDICT?
“Give it a crack. It keeps you organised, on top of your numbers, and takes the pressure off. It’s one of the only tools I’ve used that actually suits how we work in construction.”


















MIND YOUR BUSINESS

MT ALEXANDER Timber & Hardware is the go-to when it comes to the hardware needs of Castlemaine and the surrounding areas. But its roots run deeper than that, as The Tradie discovers the value of grassrootsminded suppliers who put community at the heart of their business.
We recently caught up with General Manager Brad Maltby, who has been with Mt Alexander Timber & Hardware for the past
two years, to hear how the business has evolved.
Established in 1993, the store originally traded as Beards Hardware, until Mt Alexander Timber & Hardware purchased it in 2017.
“Beards had a longstanding presence in the community, and we knew that we needed to continue to provide great service and products to our customers,” Brad said.
Since the purchase, Mt Alexander Timber & Hardware has extensively renovated the premises,
restocked, acquired additional land and vehicles to ensure that they could grow with the demand and needs of their customers.
The store’s customer base is wide and varied, ranging from experienced trades and DIYers to everyday retail shoppers. With an extensive timber, hardware, plumbing, and nursery range, Mt Alexander Timber & Hardware is a one-stop shop for the community. Being situated in Campbells Creek, just
outside Castlemaine, the store plays a vital role with the next closest alternatives over half an hour away.
“We’re competitive on pricing, and our product range is strong,” Brad explained.
“But our real point of difference is our staff and their deep connection with the community. We employ local people, we’re locally owned, and profi ts flow straight back into the community. We’re heavily involved in sponsoring sporting clubs, men’s and women’s sheds, schools, and the arts. We genuinely care about our customers and our responsibility to be part of the fabric of the community.”
community.
PART OF THE FAMILY
Mt Alexander Timber & Hardware joined HBT National Buying Group at the time of the purchase and rebrand in 2017. Along with new vibrant signage across the storefront and inside the business, being part of HBT brought fresh opportunities to grow. The decision to join was simple.
“The freedom HBT offers was the main drawcard” Brad said.
“We still get to choose our own suppliers and negotiate pricing. If we


want to support a local supplier, we can. HBT’s philosophy really aligns with our own, they value small businesses and understand the challenges we face in a rural area. But they also provide us with the support and tools we need to thrive.”

Much like Mt Alexander Timber & Hardware, HBT prides itself on empowering locals and building strong supplier relationships. Its model ensures independent stores can remain competitive nationally while still keeping profi ts in the community.
“The benefi t to our customers is clear,” Brad added.
“Through HBT, we’re





why does
JUST LIKE quality is at the heart of every tradie’s workmanship, quality is the centre of how Kennards Hire handles business.
For making sure everything’s above board, from equipment maintenance to site presentation, Kennards Hire has Quality of Operations Management (QOM).
“QOM is a well-ingrained process of auditing our branch network,” Kennards Hire Head of Operational Improvement Josh Hensby said.
“There’s a team of auditors — at least one in every state/territory — and they’ll go to each branch across Australia and New Zealand three times each per year.
“They’ll spend at least the entire day there, going through all of their processes and systems to make sure they’re ge ing things done right.”
Josh worked with the QOM team for nine years as Quality and Audit Manager, and stated the importance of having an independent auditor was vital to each branch’s longterm success.
“They’re not part of a branch’s team, so you know that the auditor won’t be swayed by anything.”
The auditor will score the quality of four different categories:
• administration,
• people and safety,
• equipment, and
• the hire centre itself.
“At the end of every round, each branch is
graded,” Josh added. “Every single branch is given feedback on areas for improvement.”
Josh said QOM gives tradies — and all Kennards Hire customers — peace of mind knowing their local branch is being regularly quality-checked.
“We also frequently survey our customers, and their reviews all regularly score in the high nines (out of 10) on average across the board,” Josh said.
“We want to be the best hire company in the world, and these processes and feedback reflect that.”
QOM is also important when it comes to ensuring each branch has a wide variety of equipment to support a variety of projects, from DIY, tradie jobs all the way up to major commercial construction.
From temporary fencing to forklifts, Kennards Hire has more than tradies realise when it comes to equipment range.
“Every piece of gear that goes out on hire and
returned is inspected,” Josh said.
“If it needs servicing, we’ll get that done and make sure its fully functional, safe and ready to go again.
“We set a target time frame to ensure the equipment is turned around and ready for hire in the best condition possible.”
For the moment, Tamworth’s Kennards Hire is top QOM dog.
The branch won this year’s Group Branch of the Year, taking top gong of branches across Australia and New Zealand.
“It was an amazing feeling, it really means a lot to me and my team,” Branch Manager Chris Farleigh said.
“It’s something we focus on every day.
“We come to work every day and do our best for our customers.”
The Tamworth Branch has been open since 2018,
Kennards Hire Group Branch of the Year Award - Tamworth, NSW Back L-R Cam Kennard, Rory Kennard, Craig McMahon, Stuart Dean, Nathan Venables Front L-R Bill Whitehouse, Andy Kennard, Margie Haseltine, Chris Farleigh, Andrea Martens, Nicki Page
with Chris moving across from Coff s Harbour to manage it in 2021. He said thanks to the dedicated fi ve-man team, Tamworth has been able to climb the QOM rankings every year leading up to this triumph.
“We all want happy customers, so QOM is there to ensure that our customers have a good experience, whether it’s good equipment, or exceptional service,” Chris said.
While most customers won’t know a QOM from a quokka, Chris said the end product of a high-quality experience was all that ma ered.
“I assume most customers don’t have a clue what QOM is,” he said.

Each Kennards Hire branch is thoroughly audited across a number of sections, including ensuring the wide range of equipment is kept in top shape
“They’ll see the auditor walking around checking things and ask, ‘what’s going on?’
“We explain it’s an internal audit system, but ultimately what the customer really gets out of QOM is a good experience with Kennards Hire.”
Kennards Hire branches are continuing to find ways to improve, with Josh saying each branch is given feedback on what they can improve upon.
Overall, however, he said the system provides a transparent way for every

Kennards Hire branch to demonstrate proof of quality to their local clientele.
“The branches live and
breath QOM,” he said. “They’re passionate about it, they really are. Every branch really wants to succeed in that area.”




CARPENTRY EXPO
provided important connections and epic products for carpenters in its first year.
Co-hosted by Carpentry Australia and Prime
Creative Media; Carpentry Expo blended innovative ideas, awesome powertools and a bit of fun at Melbourne’s Convention and Exhibition Centre.
The event kicked off
with students from Melbourne Polytechnic, Swinburne University of Technology and Holmesglen participating in a ‘build-a-bridge’ competition, televised by

Channel NINE’s Today and joined by The Block 2024 contestants Ricky and Haydn.
“The exposure that we’ve been able to build for the industry has been really notable, and connecting the trade schools through the challenge has been a win,” Carpentry Australia Head of Development Nathan Quinn said.
“Giving them exposure not only helps them at a school level, but also parents who maybe watch the TV show that can then be passed on to start conversations, which was one of the goals of the show.
“One of the bonuses has been the collaboration between exhibitors to
support each other and find opportunities. I heard that numerous times.”
The expo had its fair share of footy fever with footy royalty — former Essendon coach Kevin Sheedy and former Richmond defender Alex Rance making appearances.
Many tool brands such as ITW displayed their latest products including the Ramset’s TrakFast 65 and NEW Buildex Bugle Ba en Screws.
The TrakFast 65 is Ramset’s most powerful gas-powered cordless tool, delivering an awesome 105J of impact power in every shot.


The new ba en screws include a ClimaShield® Class 4 coating, which keeps them protected from the harsh and varied Aussie outdoors.
“We’ve been showcasing our new beautiful ba en screws,” ITW’s Laura Branson said.
“It’s our new high performer. It has the Dual Type 17 Tip with the hex head recess, which is much more firm for the tradies.
“We’ve got a clearing thread too, so it’s a much quicker, and it’s been real popular out there in the market.”
Bombers coaching legend (and Tigers Premiership player) Kevin Sheedy gave the opening address at the expo
Tradie software solutions platform NextMinute had things covered on the tech side of things.
CEO Alex Jenks was on-hand to showcase NexMinute’s new mobile app features.
“[it’s] making it really simple and easy for tradies to carry around their whole digital toolkit right in their pocket,” he said.
“It also helps in
ITW showed off its latest products to a endees — Ramset TrakFast 65 and NEW Buildex Bugle Ba en Screws



Chippies were able to check out the latest products across tools, materials and tech







connecting their crew — that’s a big thing for us.
“We’re looking at Bunnings integrations and checklist features we’re specifically looking at for the Aussie tradie.
“What we really wanna have now is an app that’s so simple, the training’s really easy that tradies can just pick it up — they’ve got it and it’s done.”
STAGE IS SET
On the expo’s groovy and unique stage, industry experts discussed everything from mental health, training and skills gaps to digital tools for chippies.
Nathan said being able to watch the expo come together in a meaningful way was awesome to see.
“It was great having
Sheedy come along in the morning of opening day,” he said.
“We’ve achieved our goal, absolutely, of not only promoting the trade to the general public, but also showcasing the training and the support for carpenters in the industry and what the future looks like.
“What we’ve heard and

the feedback, everyone’s really excited.
“It’s been remarkable because everything’s focused on the builder and the bigger companies, but it’s great to be able to provide a support expo for some of the smaller businesses and the ones who need the most support but haven’t had it before.”








THERE’D BE few be er ways to get apprentices into the trade than by having them tinker with Supercars.
That’s the opportunity Walkinshaw Andre i United (WAU) Foundation Academy has for those who feel they’re up to the task.
“WAU Foundation Academy was something we conceived to help grow young people into our sport to bring young talent through,” WAU CEO Bruce Stewart said.
“And it’s not just drivers, it’s also engineers,
mechanics, commercial people.
“We see so much opportunity in the sport to have people grow long term careers.”
Apprentices working in the Academy start off working in the Toyota GR Cup Race Series before moving into Super2 and finally the big leagues in Supercars Championship Series.
“And the beauty is, is that the whole way, they’ve been mentored by senior, more experienced

engineers or mechanics or commercial people in the team,” Bruce added.
“In that respect, they learn how we operate and what processes and programs we use to make sure that we constantly improve.”
The Academy is no cakewalk either, with apprentices working on plenty of complex critical tasks and race projects.
“We’ve had young engineers assisting in the design, but also in the production of prototypes, including things like taillights, wing mounts etc,” Bruce said.
“They also help with the design and manufacture of key items that we need that are in short supply, but need fast turnaround.
“They’ve been integral in helping us get to the line.”
Supercars will welcome the Toyota GR Supra to the lineup next year, which has meant WAU Academy apprentices have had the
The Walkinshaw Andre i United Academy supports apprentices across a bevy of trades, from the pits to the labs
Truck Assist is a major supporter of both the Walkinshaw Andre i United Racing Team and its Academy
chance to get an inside look at the new race cars.
“Our Toyota Supra Supercar project is going extremely well, and it’s on the back of some very talented young people, guided by our technical team, who have got a huge amount of experience that has meant that we are well on track,” Bruce said.
The Academy has seen plenty of talent flourish, including young Supercars Wildcard speedster Zach Bates and current Walkinshaw Andre i United driver Ryan Wood.
With many trades experiencing a shortage, Bruce said the WAU Foundation Academy was a great way for would-be apprentices to see what opportunities await them in the wider industry.
“It clearly works well for us, as well, because the team has a ready-made pipeline of amazing young talent to step into the breach if we have someone who can’t make it around or someone who chooses another career direction,” he said,
“It’s certainly been fantastic in that respect. But the biggest impact has been having that youthful exuberance, enthusiasm and energy around the
team, and it’s a selffulfilling prophecy.
“Even though you’re bringing through youth and inexperience … you’re actually gaining so much in terms of culture, the way a team operates and the general energy that it’s been an unintended consequence but absolutely pleasing to see.”
As well as paving the way for apprentices to carve out a career, the Academy also empowers those who might come from financial or geographically challenging backgrounds get into the industry.
“I wish we could make it wider for the young talent,” Bruce explained.
“I wish we could do more … we run a lot of events like Girls on Track, and a lot of workshop events where we open our doors for young talent to come and see.
“I can see the wealth that the universities and the TAFEs are growing in these areas, but we’re a team of 52 people, and you know, I only have a few internships a year.
“We’ll continue to push to grow it as much as we can. And the by-product is that we get young talent through who also might not have the financial backing to make it, but we’re picking the cream of the crop and giving them financial support to be able to take the next step in the career.”


IN THIS FEATURE we wind things back to the most ancient of art forms.
Rooted in the simplicity of walking to catch a fish and sharing the proceeds with family and friends.
In this feature I’m handing over the reins to one of my most passionate fishing buddies, Andy Steele.
A long time blue water guide and one of those fishy characters who seems to have a magnet on his lure, lets cross over for a li le first person insight from the man himself.
Land based fishing is one of the oldest forms of the sport. Throughout history and across the globe, humans have fished from the shores of rivers, beaches, lakes, estuaries — even off the frozen sea ice in the northern extremes. Originally done for survival, today it's mainly about the passion for the sport and the thrill of the chase, catching our target species from solid ground.
Whether you're standing on a rock ledge, walking the edge of a riverbank or my personal favourite, stalking the sand flats or beaches near your local area.
The excitement of fishing with terra Australis under your feet gives an adrenaline rush like no other.
Chasing might be harder and the fish not as plentiful but when it all pays off the reward is so much sweeter.


In the northern part of the country we are blessed to have a vast expanse of tidal flats reef flats or sand flats around the coast.
These areas are known as intertidal zones and an abundant variety of fish species push into these areas to feed, depending on the ebb and flow of the tide making them accessible to land based fishos.
Water pushing up onto a sand or mud flat, into the mangroves or a deep beach gu er gives fish the opportunity to hunt.
The array of tasty shrimps, crabs, worms, bait fish and all sorts of goodies that hide beneath the sand or in mangroves.
Predators include golden trevally, giant trevally (GTs), gold-spot trevally, diamond trevally, emperor species, cobia, blue bastards, queenfish, Permit and blackspot tusk fish. Each of these species and more can be targeted with either a light spinning outfit or flyfishing outfit.
For those who love the challenge, walking the flats with a fly rod is about as good as it gets. It can be relaxing and yet exciting at the same time.
It takes me back to when I was a kid walking around the local lagoon at Terrigal on the NSW central coast,
catching sand whiting and bream on small hand tied flies after school.
All you need is your rod, a few flies, some polarised sunglasses and the weather on your side as sunshine is essential for good sight fishing on the flats.
The anticipation of walking a deserted beach or your favourite flat on a sunny day with a perfect neap tide is pure bliss.
Scanning the water for any sign of life, any movement or shadows, a silver flash, a flicker of bait or a tail of a feeding fish breaking the surface as it digs for food will make any fisherman giddy with excitement.
Blue bastards as they are commonly called are endemic to northern Australia, meaning it's the only place in the world you can catch them.
They have only recently been discovered as their own species in 2015, although Aussie fly fisherman have been targeting them for decades.
They get the name from their behaviour and looks, with a beautiful blue tinge to their cheeks and yellowish eye flush. They are very clever, ski ish, spook easily and can be very difficult to hook.
And once hooked, they are masters at finding the only



piece of structure or cave for miles around to bust you off on... hence the name blue bastards!
These fish have become my latest obsession and I've learnt a lot over the last few years chasing them, watching their behaviour and learning what and what not to do. Casting at a blue bastard that is simply swimming along perpendicular to the seabed will 99 per cent of the time result in you spooking the fish.
Whether it's him seeing your line as you cast, the shadow off your rod or simply the splash of the fly hi ing the water they are out of there quick smart and your back to square one searching for another opportunity. When you do come across a blue bastard or any other demersal fish in the shallows the key is not to rush, take your time, watch the fish and track it’s movement.
Sometimes it can feel more like hunting than fishing as your stalking your target waiting for the right opportunity to cast.
What you’re looking for is to see them start feeding.
They dip their head down and tail up (tailing) and start digging around for food in the sand, mud or coral.
This is your casting window, now that they are distracted the chances of you spooking that fish are drastically reduced. this is when you want to make your cast.
Try to land the fly just in front of where they are digging. Let it sink to the bo om, the idea is that they think they've dug it up themselves and if you place it correctly they will usually suck it down you'll feel a slight tap on the line now it's time to strip strike and then chaos unfolds.
As you come up tight and before you know it, fly line is screaming off the reel as an explosive bow wave of energy surges off their shoulders as they scream off in search of deeper water or structure to hide in.
You’re into your backing, knees trembling, adrenaline rushing throughout your body, there is no be er feeling then the giant gleaming bastard laying on it’s side at your feet.
My go to setup is a 10wt fly rod and reel, intermediate line and 9 foot straight through 40lb leader. I prefer to use shrimp pa erns over a crab pa ern, not just for blue bastards, but because they work equally as well when a pack of hungry GTs or a school of queenfish turn up and you need to strip it fast.
Crab flies tend to spin and twist on a fast retrieval.
Opportunities can present themselves out of nowhere on the flats and can disappear just as fast.
Having time to change a fly before the casting window is over for these speeders of the flats is usually not an option.
While on the flats larger animals such as rays or schools of sleepy sharks are your best friend.
These are like naturally occurring FADs (fish aggravating device) on the flat.
As they come up to feed in the shallows, these large moving objects usually have company, whether it be schools of Golden trevally or GTs or even Permit following along picking up scraps or catching small fish and tasty morsels that are disturbed by sharks and rays as they puff up the sea bed in search of their own food.
I started my land based fishing career as a four-year-old boy beach fishing with my old man on the NSW central coast. Although I can't remember my first fish as I was so young, dad still has the old 6" by 4" photo of me holding up a pink snapper smile from ear to ear.
Most Christmas lunches will result in dad telling the story of how I caught this beauty. When I hooked up and drag started coming off the reel, I didn’t know what to do or understand the winding part of the operation, so I did what any four-year-old would do. Started running up

the beach with my rod, by the time I got to the sand dunes behind us, to dads surprise, one of the biggest snapper he had seen came flapping up the sand beach. From then I was hooked.
Recently I had an experience not considered a possibility. Strong relentless trade winds and spring tides had pushed a sand bank I’ve fished in the past out further than usual, thus making it possible to cast into quite deep water right off the sand.
Equipped with my light spin stick, a 3000 sized reel, 20lb braid, mono leader and a li le shallow bibbed lure I intended on spending the afternoon flicking for queenfish, small trevally and possibly a coral trout for dinner.
Well I was in for a surprise!
After my friend landed a nice queen fish, excited the very next cast I hooked something. It felt solid but also didn't do much to start, as if it didn't know it was hooked. Then it started screaming off so fast I wasn't sure if my fish had just been eaten by a shark. I played it cool and took my time. After another blistering run I realised this was not behaving like any shark I’d caught, rather more like a spanish mackeral.
The speed, the tail beats and the way it was staying up in the water column away from the sharp coral. I dared to dream, land based mackerel would be a first for me and this thing felt huge.


After retrieving 60 or 70 meters of line back on the tiny reel yet again it screamed off. Heart in my throat thinking any second now it’s all going to be over and it will bite me off. In this case patience and a calmer head prevailed.
The key in these light line, big fish scenarios is not to rush, take your time. After a 10 minute ba le I could see the fish and indeed it was a massive Spaniard.
My friend assisted in grabbing him by the tail by this stage the beast was just about spent of all energy.
And there it was, a 35lb Spanish mackeral caught off the sand on a light spin stick. I was speechless and spent, an epic shore ba le and one for the long memory bank.
The magic of land based fishing is not just about the catch, it’s where it can take you. The journey you take to get there is often half the fun. Australia has some of the most varied and vast coastlines in the world and some of the most beautiful land-based fishing destinations on the planet.
The thrill and the addiction is that there is always something bigger, be er, harder, more challenging and more remote. It’s a sport that keeps us coming back time and time again.
Fishing as a sport is always evolving yet there will always be a place for the simple practice of catching your quarry from Terra Firma.
It’s the memory most small kids experience when dragging their catch up on the bank and staring in bewilderment. The idea that a combination of skill, luck and local knowledge can put something tasty in the bucket to eat for dinner. Priceless.
and reef




construction, landscaping, woodworking, sheet metal fabrication, heavy cleanup work, manual labour or jobs simply involving power tools should look for gloves with both cut and impact protection.
Hand impact, crush, cut, and laceration injuries top the list of hand injuries across the world.
Having the right impact & cut glove combination can protect your hands from knocks, blunt force impact, crushes, severe cuts and puncture.
But with more and more on the market, which
impact and cut protection glove should you choose?
With several options available, the trick is to find work gloves with the right combination of specialised features to meet the unique demands of your work conditions.
Just as important, you also need your gloves to be comfortable and fi t you right.
Here’s what you need to look for when choosing impact and cut-resistant gloves:
PROTECTION
Impact-resistant gloves
have extra layers of materials on the back of hands — often different densities of both foam and performance rubbers — that are specifically designed to absorb shocks, heavy blows as well as vibration from power tools. Look for protection which covers the full length from the back of the fingertips to the knuckles and back of hands.
The best anti-impact gloves will protect you not only from impacts, but from cuts, punctures, blisters, chafing, and bruising too.
Depending on your work, you might want to look for impact-resistant gloves that also have additional features.
For example, jobs that involve wet or oily surfaces require gloves with reliable grip control.
Cut resistant gloves can have optional-full 360o degree protection or only 180o across the full palm surface.
Level F cut protection offers the highest tested level of resistance against cuts, which is specifically graded from the industry
Get the right grip on safety with cut and impact-resistant gloves designed to protect your hands from knocks, cuts, and punctures on the job site
standards of protective gloves against mechanical risks. EN388: 2016.
FLEXIBILITY
For many jobs, it’s important that your hands still have their full range of motion, so you also want your cut and impact protection gloves to be as flexible and comfortable as possible.
Gloves with lightweight liners, that also provide good breathability are important for dexterity and comfort – especially in hot environments.
Gloves that are touch screen compatible are also a must on most job sites these days.
FINDING THE RIGHT FIT
Gloves that don’t fi t you properly will be uncomfortable, but they can also be unsafe.
Ill-fi ing gloves can cause long-term injuries or even short-term injuries like muscle cramps, fatigue, and blisters.
Gloves that are too big are likely to slip, and gloves that are too tight will restrict your range of motion.
To determine the right size glove, measure both your hands, and look at brand sizing charts before making a purchase.
LOOKING FOR THE BEST IMPACTRESISTANT GLOVES? Finding the perfect pair of gloves means balancing

Experience top-tier protection and dexterity with gloves like the Ninja FA6, featuring Level F cut resistance and advanced grip technology to keep you safe and productive
a list of factors, including protection, comfort, durability, dexterity, and more. It’s worth doing some research and investing in the right pair.
One standout option on the market today is the Ninja FA6- Impact Cut F glove.
Crafted from fine 18-gauge Kevlar liners, these gloves offer a snug fi t akin to a second skin while providing top-tier Level F cut protection.

Enhanced with a new foam technology coating for superior grip, abrasion resistance, and breathability, they are further fortified with a resilient high performance rubberised impact design ensuring solid protection against impacts.







HAVE YOUR SAY

Carpentry Expo at the Melbourne Convention and Exhibition Centre on September 17th and 18th


was a huge hit, bringing together carpenters, apprentices, industry leaders, and suppliers for a couple of action-packed days.
Kicking off with a live broadcast on Channel 9’s Today show, the event set the stage for a celebration of everything that makes carpentry such a dynamic and essential trade.
One of the standout moments from day one was the Pryda Bridge-Building Competition. Students from Holmesglen,
Melbourne Polytechnic, and Swinburne University went head-to-head to build a bridge structure on the expo fl oor.
With Kevin Sheedy, a true Aussie icon, on hand to judge, it was an event that had everyone talking.
After a fierce ba le, it was Melbourne Polytechnic who took home the win, proving their skills and se ing a high bar for future competitions.
The competition didn’t stop there.
The Selleys Wall Challenge added a bit of extra fun to the mix.
Participants had to remove a toolbox that had been stuck to a wall using Selleys’ super-strong adhesives.
While many tried, it was a carpentry student who finally succeeded, though it wasn’t easy.
In fact, they had to rip off the back panel of the unit to get it off, because nothing can beat the power of Selleys.
Throughout the expo, there were heaps of insightful sessions on offer, including talks on women in carpentry, tech solutions for tradies, and grants and financial aid.
The team at Milwaukee Tools presented “Forever
Carpentry Australia’s Head of Development Nathan Quinn and CEO/Founder Jake McArthur opened up about many of the initiatives the association is engaged in nationally
for the Trade”, and there was an interesting panel on building your work pipeline that gave everyone plenty to think about.
Day Two was just as packed, with sessions on mental health in trades, redefining success in carpentry, and apprenticeships and skills gaps.
For anyone looking to up their game, the session on drafting and negotiating contracts was a musta end, offering practical advice for protecting your business.
None of this would have been possible without the incredible support from our sponsors.
A massive thank you
to 48 Tools, STABILA, Milwaukee, Carbon Warrior, Chisolm Institute, Dahlsens, Pryda, Holmesglen, Selleys, Bendigo Bank East Ivanhoe, Loop Logics, ITW, Melbourne Polytechnic, Swinburne University of Technology, Intergrain, Hamer Finance, Orange College, Paslode, Sydney Builder Chick, Next Minute, and EkoDeck.
These guys made it all happen, and we’re stoked to have their support.

Looking back, the Carpentry Expo was a massive success. It brought together people from all corners of the industry, sparked new ideas, and reinforced the importance of community
within the trade. If you missed out, don’t worry, next year is already shaping up to be even bigger and be er.
See you there!
Everyone has a gift, and at TAFE NSW we want to help you find yours with building trades courses taught by industry-experienced teachers. Our nationally recognised qualifications will give you the practical skills to construct a successful career.
Explore courses in:
+ Electrotechnology
+ Renewable energy + Bricklaying and blocklaying
+ Wall and floor tiling + Air-conditioning and refrigeration + Plus many more building trades.
Enrol now for Semester 1, 2026 with TAFE NSW.
If you want to understand how Carpentry Australia can support you, call us 1300 562 779 or visit carpentryaustralia.com.au FIND




NAWIC has boots on the ground in every State and Territory and continues to be at the forefront of driving positive change to benefi t women and underrepresented groups in the construction sector.
We were excited to partner once again on the


Women in Construction, Engineering & Infrastructure Summit in Melbourne in August.
Along with endorsing partner National Women in Transport, NAWIC’s nominated charity partner for the event was the Tradeswomen Australia Group.
The summit provided an opportunity to network and hear from an impressive list of speakers across the two days.
It was a pleasure to emcee the event and moderate some fantastic sessions, present the opening address and share findings from NAWIC’s “Not So Li le Things Affecting Women in Construction” microaggressions research report.
Session topics included fostering inclusive leadership, career advancement, CEOs driving the culture change, cultivating networks, rising together through allyship, inclusive and respectful workplaces, an inclusive supply chain showcase, and the critical need to focus on issues impacting retention.
Shifting the dial for women in construction means tackling the diffi cult issues with people at all levels from those working on the tools and all the way up to senior leadership.
As the peak membership body for women working in the construction sector we are commi ed to
creating fair, inclusive and respectful workplaces where everyone can thrive.
At the end of the financial year, we had 360 organisational members, more than 16,000 members and about 400 volunteers with membership renewals now well underway and new members are always welcome.
Membership is open to all – women, men, nonbinary people, apprentices and organisations – and provides access to a range of member benefi ts like discounted event tickets, mentoring programs, professional development, awards, resources and much more.
We are also preparing to roll out our innovative Allyship in Action: Transforming Culture to A ract and Retain
NAWIC CEO Cathryn Greville and a endees at NAWIC’s 30 CEOs for 30 Years Roundtable in Melbourne on National Equal Pay Day
Women project, which was awarded $5 million in funding from the Federal Government’s fl agship Building Women’s Careers (BWC) Program.
The three-year long project will engage men as partners and tackle poor a itudes and behaviours; empower men to sponsor women into leadership; and utilise the power of cultural ambassadors of all genders to embed positive change on the ground.
Each of us can make a difference in our workplace.
Culture change starts with understanding and sharing what is working, what is not and what opportunities we have to explore.

I was truly honoured to be named the Construction Sector Gender Equity Champion of the Year 2025 in APAC Insider’s Australian CEO Excellence Awards in August.
The awards celebrate the exceptional leadership and innovation that has positioned Australia as a global powerhouse in a rapidly evolving world.
They recognise the contributions of CEOs who are not just steering their companies to success but are also shaping Australia’s economic and
societal landscape.
This award is a reflection on the work of the entire NAWIC team past and present, including our staff, board members, members and volunteers across the country. In our 30th Anniversary year, we have been considering what’s been achieved so far and our vision for the future of women in construction.
We have big plans for the coming years, and I thank everyone for their ongoing support. Our theme in our anniversary year is ‘Individually We Inspire, Together We Rise’
and this was one of our key messages at our 30 CEOs for 30 Years Roundtable on National Equal Pay Day in Melbourne.
The day marked the end of the 50 additional days into the new financial year that women in Australia needed to work to earn the same pay, on average, as men.
The Roundtable was an integral part of implementing our new organisational strategy as we reflect on the current state of the construction industry and what is needed to ensure we a ract, retain and

advance women plus see the entire sector reach its full potential.
The session provided a unique opportunity for us to discuss common challenges with CEOs and leaders in the construction sector to explore ways in which we can collaborate to drive meaningful change and collective impact. It was wonderful to have support and representation from across the sector.
CEOs and leaders have an important role to play in driving gender equity. The insights from the Roundtable will be
NAWIC CEO Cathryn Greville has been named the Construction Sector Gender Equity Champion of the Year 2025 in APAC Insider’s Australian CEO Excellence Awards. She is pictured at NAWIC’s National Awards for Excellence 9 May 2025
NAWIC CEO Cathryn Greville at the Women in Construction, Engineering & Infrastructure Summit in Melbourne with Communications Engineer at UGL Kate Leone and Human Resources Director at GS Engineering and Construction Penny Arnold. NAWIC’s nominated charity partner for the event was the Tradeswomen Australia Group
pivotal in helping help us build our collateral, our resources and our training for members to ensure we meet the needs of the sector. And we need your insights and experiences too to support us in our advocacy work – so join us as we work to create a fair, inclusive and respectful industry.
Our membership year runs through to 30 June 2026 but it’s not too late to sign up or renew if you haven’t done so yet
YOUR SAY!

AS WE hurtle towards the end of Term 3, we wanted


to share the highlights of the work EWIT has undertaken in the school space this term.
The final school’s-based programs have been booked for early term 4 as we count down the days to summer and the end of another school year. We know that exposure and experience spark possibility.
Our three most recent school engagement sessions brought the world of trades to life for students across
Melbourne’s north-east and in Mount Gambier, South Australia. Making space to show students that every career path begins with curiosity, courage, and a li le handson action.
At Melba College in Melbourne, Year 10 students rolled up their sleeves for immersive activities in electrical, plumbing, brickwork, tunnelling, woodwork, and engineering. Inspiring role models including Olivia and Rhi from NBN Australia shared their journeys, proving that stepping outside your comfort zone can open unexpected
doors. Penny from APM Apprenticeships and Miranda from Future Energy Skills highlighted the real opportunities awaiting women in underrepresented industries.
The students’ excitement spoke volumes: “I loved being a plumber for a moment and making a toolbox — so useful!”
Meanwhile, at Templestowe College, the Eastern Freeway Burke to Tram Alliance team partnered with EWIT to showcase civil construction pathways to students and connect them to opportunities on
the Victoria’s Big Build projects.
Students explored both VET and university pathways and discovered essential workplace skills including leadership, teamwork, planning, and problem-solving. Combining technical skills with employability skills are an important representation of a modern-day workplace. EWIT marked a major milestone in Term 3, delivering its first dedicated school program outside Victoria and Mount Gambier didn’t disappoint! In partnership with OneFortyOne, eager Year 9 and 10 students from explored the full story of timber from forest to finished product. The day began with forestry professionals sharing their career journeys, followed by hands-on electrical and mechanical trade activities that had students testing their skills and teamwork. A guided tour capped off the experience, connecting classroom learning to real-world industry.
The result? Students left inspired, confident, and aware of the exciting career pathways in forestry and trades — a reminder that timber shapes nearly everything around us. These experiences aren’t just about tools and timber, they’re about confidence, connection, and future pathways.

IN AN industry built on skill, precision, and pride in workmanship, recognition goes a long way.
That’s why each year, painters, decorators, and industry leaders gather in Brisbane for the Master Painters Association Queensland Excellence Awards — a night that


celebrates more than just the best projects of the year.
It’s a stage that showcases the very essence of craftsmanship in our trade.
Behind the black ties and gala dinners is something bigger: the awards have become a benchmark of quality and a catalyst for business growth.
For Painters, the benefi ts of being a finalist or winner go well beyond the awards.
RECOGNITION
Clients want assurance that the tradespeople they hire are at the top of their game. Being recognised by the industry’s peak body instantly builds credibility and trust, positioning businesses as leaders in their field.
TURNING THE AWARDS INTO OPPORTUNITY
An award finalist or win isn’t just something to hang on the offi ce wall — it’s a tool for market diff erentiation.
Businesses use their recognition to negotiate
be er contracts, secure premium projects, and stand apart in a competitive market. For some, the exposure leads directly to new partnerships and growth opportunities.
BOOSTING THE TEAM BEHIND THE TOOLS: TEAM MORALE
The Excellence Awards also shine a light on the people doing the hard yards. For business owners, sharing that recognition with their crew can lift morale and strengthen workplace culture.
The Master Painters Association Queensland Excellence Awards celebrate the best in the industry
Business become an employer of choice, improving retention in an industry where skilled labour is gold.
NETWORKING THAT COUNTS
With hundreds of painters, suppliers, and decisionmakers in one room, the awards have become a unique hub for building industry connections.
Many a endees say the real value lies in the conversations and relationships forged during the night.
The MPA Excellence Awards have evolved into more than just a night out—they represent a platform where craftsmanship meets opportunity, helping to raise standards and builds pride while driving business success across Queensland’s painting and decorating industry.
For those in the trade, it’s a reminder that excellence isn’t just about the finish on the wall — it’s about building a professional industry built on skill, reputation, and trust.


PRIME MINISTER
Anthony Albanese welcomed members of the 2026 Team Australia Training Squad to Parliament House on

Trevor
Schwenke CEO, WorldSkills
Australia
September 1, where he spoke with them about their aspirations and posed for photos, wishing them well as they prepare for WorldSkills Shanghai 2026.
The meeting was followed by the offi cial launch event inside Parliament House, a ended by Training and Skills Minister Hon Andrew Giles MP and close to 200 leaders from government, education and industry.
The spotlight was on 39 outstanding young
apprentices, trainees and professionals along with 35 dedicated experts from across Australia, each of whom earned their place after excelling at the 2025 National Championships in Brisbane.
The evening began with an inspiring address from 2022 Skillaroo Rachel Crawford, who shared her journey with WorldSkills that saw her become the first Australian to join the WorldSkills Champions Trust representing ASEAN/Oceania.
Rachel spoke about the opportunities the movement has created for her and encouraged young people everywhere to follow their dreams.
Following this, Minister Giles congratulated the Training Squad on their achievements and highlighted the importance of the VET system in shaping Australia’s skills future. He also reaffirmed the Government’s support for WorldSkills Australia before being presented
Squad
with a Team Australia jacket.
The evening featured a dynamic panel discussion with the Skillaroo Training Squad members, who offered powerful first-hand insights into their journeys so far. They reflected on their expectations for the upcoming International Competition in Shanghai and highlighted how WorldSkills Australia programs have


transformed their personal and professional growth.
Members of Parliament from across the country, including those representing the squad members’ home electorates, a ended the event, underscoring the national significance of the achievement.
Also in a endance was WorldSkills Australia’s Patron and former Minister for Skills and Training, Brendan O’Connor.
WorldSkills Australia
CEO Trevor Schwenke said the evening was a fi ing way to recognise the achievements of the Team Australia Training Squad.
“This was an outstanding event and a great honour to celebrate in Parliament House,” he said.
“Our Training Squad has worked tirelessly to reach this point, and they are genuinely excited to potentially represent Australia on the world stage.
“I want to thank Prime
Minister Albanese, Minister Giles, the MPs who joined us, and all those who made the team’s visit to Parliament House such a memorable one.
“Their support means a great deal to our competitors as they prepare for Shanghai 2026.”
The Parliament House event capped off a fourday development camp, where squad members developed teamwork, resilience and high-
performance skills. A special visit to the Australian War Memorial offered the group a chance to reflect on service, sacrifice and national pride — a poignant reminder of the honour that comes with representing Australia on the global stage.
The Training Squad got well acquainted with Parliament House
Check it out! Check it out!
Stay up-to-date with WorldSkills Australia events and competitions, visit worldskills.org.au

grow taller, building owners are turning to maintenance solutions that reduce cost and disruption. Rope access — using industrial abseiling techniques to reach facades — is increasingly being adopted as an alternative to traditional scaff olding.
Anchor Safe Rope Access operates across both Melbourne and Sydney. The company is recognised by the Master Painters associations, provides a window into how the method works and why it is gaining traction.
BDM - Design and Estimating Manager Brad Love has worked in the building industry for more than half a century.
“I’m a painter and decorator by trade, a spray painter,” Brad said.
“Most of the team are also trade-qualified, so we’ve got an enormous

pool of information and experience to draw on.”
Anchor Safe Rope Access employs 35 rope access technicians and 14 admin and technical staff across its Melbourne operation.
According to Brad, this trade background allows the team to handle tasks ranging from painting and remedial work to waterproofing and façade inspections.
Brad discussed an eightstorey apartment project where scaffolding created significant complications.
“The retail stores at street level saw their trade drop by about 25 per cent because everyone thought it was a construction site,” he said.
“Residents were staring at ugly grey and green mesh for months — and then the builder went broke, leaving the scaffolding in place.”
By contrast, rope access requires no large structures.
“Our only obstacle is a technician working off a rope,” Brad explained.
“We’re a li le bit like ninjas — we come in, do what’s needed, and disappear.
“At the end of the day, we pull the ropes up and the building is back to normal operations.”
SAFETY AND COMPLIANCE
The company operates within strict safety frameworks.
“Because we’re dealing with someone’s life on the end of a rope, we don’t take shortcuts,” Brad explained.
“If it’s not safe, we don’t touch it—simple as that.”
All rope access workers are IRATA certified, from Level 1 through Level 3 for complex rescues.
Brad said anchors are tested before every descent, daily toolbox talks are conducted, and all equipment is tethered to prevent objects from
falling. He also cites compliance with the Design Practitioners Act, which requires specialised design and oversight for waterproofing and other façade works.
Rope access allows close-contact façade assessments that are diffi cult from the ground or by drone.
“We put guys on ropes over the side of the building and they can physically touch the render work to see if it’s drummy,” Love explained.
“Anchor Safe Rope Access uses a proprietary inspection app to document findings.
“Where others might take ten pictures, we photograph every nook and cranny — sometimes 1,500 photos in a single
report,” Brad said.
Data is then linked to a spreadsheet for cost estimation.
The company’s work has been acknowledged by the Master Painters associations.
Brad, who prepares award submissions, said they include client testimonials and detailed project specifications.
He added that communication with residents and property managers is a core part of each job.
“Before we start any project, we le erbox all residents and set up a WhatsApp group so clients can see progress photos and stay informed,” he said.
The example of Anchor Safe Rope Access illustrates the broader appeal of rope access: reduced visual impact, fewer business interruptions, and the ability to perform complex façade maintenance without the footprint of scaff olding.










